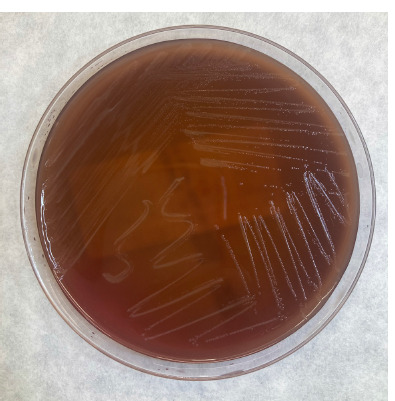

[Splenic abscess caused by Coprobacillus catenaformis. A case report].
IF 2.2
Revista espanola de quimioterapia : publicacion oficial de la Sociedad Espanola de Quimioterapia
Pub Date : 2025-02-01
Epub Date: 2024-12-04
DOI:10.37201/req/084.2024
引用次数: 0

链状副芽孢杆菌所致脾脓肿。[病例报告]。
本文章由计算机程序翻译,如有差异,请以英文原文为准。
求助全文
约1分钟内获得全文
求助全文
来源期刊
自引率
0.00%
发文量
0

 求助内容:
求助内容: 应助结果提醒方式:
应助结果提醒方式:


